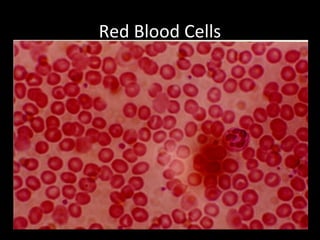
Red Blood Cells

Embed presentation
Downloaded 11 times








This document lists and compares different types of cells found in living organisms including skin cells, plant cells, onion cells, cheek cells, striated muscle cells, nerve cells, red blood cells, and plant guard cells.